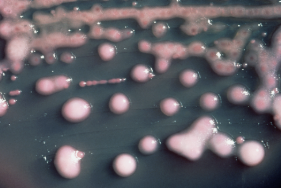

๐ ํญ์์ ๊ฐ ํ์ํ ๋, ๋ฉ๋์นด์ธํํด๋ฌ๋ ์ด๋ค ์ฝ์ผ๊น?
๐ ๋ฉ๋์นด์ธํํด๋ฌ์บก์250mg: ๊ฐ์ผ ์งํ์ ํด๊ฒฐ์ฌ
๊ฐ์์ค๋ฝ๊ฒ ์ฐพ์์จ ํ๋ ด, ๊ธฐ๊ด์ง์ผ, ํน์ ๋ฐฉ๊ด์ผ.
๋ชธ์ด ์ํ ๊ฒ๋ ๊ฑฑ์ ์ด์ง๋ง, ์ด๋ค ์ฝ์ ๋ณต์ฉํด์ผ ํ๋์ง ๋ชจ๋ฅผ ๋ ๋ ๋ถ์ํด์ง๊ณค ํฉ๋๋ค.
์ด๋ด ๋ ๋ณ์์์ ์์ฃผ ์ฒ๋ฐฉ๋๋ ํญ์์ ์ค ํ๋๊ฐ ๋ฉ๋์นด์ธํํด๋ฌ์บก์250mg์
๋๋ค.
์ด ์ฝ์ ์ธํ๋ก์คํฌ๋ฆฐ๊ณ 2์ธ๋ ํญ์์ ๋ก, ๋ค์ํ ์ธ๊ท ๊ฐ์ผ์ ํจ๊ณผ๊ฐ ์์ผ๋ฉฐ ์๋์ ์ผ๋ก ์์ ํ ์ฝ๋ฌผ๋ก ๋๋ฆฌ ์ฌ์ฉ๋ฉ๋๋ค.
์ค๋์ ์ด ์ฝ์ ํจ๋ฅ, ๋ณต์ฉ๋ฒ, ๋ถ์์ฉ, ์ฃผ์์ฌํญ, ๊ถ๊ธ์ฆ๊น์ง ๋ชจ๋ ํํค์ณ๋ณด๊ฒ ์ต๋๋ค. ๐ฉโ๏ธ๐จโ๏ธ

โ 1. ๋ฉ๋์นด์ธํํด๋ฌ์บก์250mg์ ์ ํจ๊ท ์ข ๊ณผ ์น๋ฃ ์งํ
๐ก ์ด๋ค ์ธ๊ท ์ ํจ๊ณผ์ ์ธ๊ฐ์?
- ํ๋ ด์ฐ์๊ตฌ๊ท
- ์ธํ๋ฃจ์์๊ท
- ํฌ๋๊ตฌ๊ท
- ์คํธ๋ ํ ์ฝ์ฟ ์ค ํผ์ค๊ฒ๋ค์ค (A-๋ฒ ํ์ฉํ์ฑ ์ฐ์์๊ตฌ๊ท )
- ๋์ฅ๊ท , ํ๋กํ ์ฐ์ค๊ท , ๋ฏธ๋ผ๋น๋ฆฌ์ค, ํด๋ ๋ธ์์๋ผ, ์๊ท ๋ฑ

๐ ์ ์ฉ ๋์ ์งํ์?
- ์ค์ด์ผ, ํธ๋์ผ, ์ธํ๋์ผ, ๊ธฐ๊ด์ง์ผ
- ํ๋ ด
- ๋ฐฉ๊ด์ผ, ์ ์ฐ์ ์ผ, ์๊ท ์ฑ ์๋์ผ
- ํผ๋ถ ๋ฐ ์ฐ์กฐ์ง ๊ฐ์ผ: ๋ถ์ค๋ผ, ์น์ข , ๋ชจ๋ญ์ผ, ๊ฐ์ผ์ฑ ์ฃฝ์ข
- ์์ธ์, ์ฐฝ์๊ฐ์ผ, ํผํ๋์ ๋ฑ
→ ์ ์ ๊ณณ๊ณณ์ ๋ค์ํ ๊ฐ์ผ์ ํญ๋๊ฒ ์ฌ์ฉ๋ฉ๋๋ค.
โ 2. ๋ณต์ฉ๋ฒ ๋ฐ ์ฉ๋
๐จโ๏ธ ์ฑ์ธ ๊ธฐ์ค
- 1ํ 250mg์ 8์๊ฐ๋ง๋ค ๊ฒฝ๊ตฌ ํฌ์ฌ
- ํ๋ ด ๋ฑ ์ค์ฆ ๊ฐ์ผ์ 2๋ฐฐ ์ฆ๋ ๊ฐ๋ฅ
- ์๊ท ์ฑ ์๋์ผ: 1ํ 3g + ํ๋ก๋ฒ ๋ค์๋ 1g ๋ณ์ฉ
๐ง ์์ ๊ธฐ์ค
- ์ฒด์ค 1kg๋น 20mg์ 1์ผ 3ํ ๋ถํ ํฌ์ฌ
- ์ค์ฆ ๊ฐ์ผ ์ ์ฒด์ค 1kg๋น 40mg๊น์ง ์ฆ๋ ๊ฐ๋ฅ
- ์ต๋ 1g/์ผ
๐ง ์ ์ฅ๊ธฐ๋ฅ ์์ ํ์
- ๋ณ๋ ์ฉ๋ ์กฐ์ ์์ด ์ฌ์ฉ ๊ฐ๋ฅํ๋ ์ฃผ์ ํ์
๐ ์ต์ ์น๋ฃ ๊ธฐ๊ฐ์?
- ๋ฒ ํ์ฉํ์ฑ ์ฐ์์๊ตฌ๊ท ๊ฐ์ผ: ์ต์ 10์ผ ์ด์ ํฌ์ฌ ๊ถ์ฅ
โ ๏ธ 3. ๋ถ์์ฉ ๋ฐ ์ด์๋ฐ์
์ฝ์ ํจ๊ณผ๋งํผ ์ค์ํ ๊ฑด ๋ถ์์ฉ ์ฒดํฌ์ ๋๋ค.
๐ก๏ธ ์๋ ๋ฅด๊ธฐ ๋ฐ์
- ์๋ํ๋ฝ์์ค, ๋๋๋ฌ๊ธฐ, ๋ฐ์ง, ํ๋ฐ, ๊ฐ๋ ค์, ํธํก๊ณค๋ ๋ฑ
๐ฅด ์ํ๊ธฐ๊ณ
- ์ค์ฌ, ๋ณตํต, ๋ฉ์ค๊บผ์, ์์ฅ ์ฅ์
- ๋๋ฌผ๊ฒ ์๋ง์ฑ๋์ฅ์ผ ๊ฐ๋ฅ์ฑ
๐ฉบ ํ์ก๊ณ
- ๋ฐฑํ๊ตฌ ๊ฐ์, ์ฌ์๋ถ๋์ฑ ๋นํ, ์ฉํ์ฑ ๋นํ ๋ฑ (ํฌ๊ทํ์ง๋ง ์ค์)
๐ซ ๊ฐ·์ ์ฅ
๐ฉธ ๊ฐ ๊ธฐ๋ฅ ๊ด๋ จ ์์น
1. ALT (Alanine Aminotransferase, ์๋ผ๋ ์๋ฏธ๋ ธ์ ์ดํจ์)
- ์ฃผ์ ์๋ฏธ: ๊ฐ์ธํฌ ์์ ์ ํ์ก์ผ๋ก ๋ฐฉ์ถ → ๊ฐ ์์ ์งํ
- ์์น ์์ธ
- ๊ธ์ฑ ๊ฐ์ผ (Aํ, Bํ, Cํ ๋ฑ ๋ฐ์ด๋ฌ์ค์ฑ ๊ฐ์ผ)
- ์์ฝ์ฌ์ฑ ๊ฐ์งํ
- ์ง๋ฐฉ๊ฐ, ๋น์์ฝ์ฌ์ฑ ์ง๋ฐฉ๊ฐ์ผ(NASH)
- ์ฝ๋ฌผ์ฑ ๊ฐ์์ (์: ์งํต์ , ํญ์์ , ํญ๊ฒฝ๋ จ์ ๋ฑ)
- ๊ฐ๊ฒฝ๋ณ, ๊ฐ์
2. AST (Aspartate Aminotransferase, ์์คํ๋ฅดํ ์ดํธ ์๋ฏธ๋ ธ์ ์ดํจ์)
- ์ฃผ์ ์๋ฏธ: ๊ฐ ์ธ์๋ ์ฌ์ฅ, ๊ทผ์ก์ ์กด์ฌ → ๊ฐ ์์๋ฟ ์๋๋ผ ๊ทผ์ก์งํ๋ ๋ฐ์
- ์์น ์์ธ
- ALT์ ์ ์ฌ: ๊ฐ์ผ, ์ง๋ฐฉ๊ฐ, ๊ฐ๊ฒฝ๋ณ, ๊ฐ์
- ์ฌ๊ทผ๊ฒฝ์, ์ฌ๊ทผ์ผ
- ๊ทผ์ก ์์ (๊ฒฉํ ์ด๋, ์ธ์, ๊ทผ์ก์งํ)
3. ALP (Alkaline Phosphatase, ์์นผ๋ฆฌ์ฑ ์ธ์ฐ๋ถํดํจ์)
- ์ฃผ์ ์๋ฏธ: ๊ฐ, ๋ด๋, ๋ผ ๋ฑ์์ ์์ฑ → ๋ด์ฆ ์ ์ฒด๋ ๋ผ์งํ ๋ฐ์
- ์์น ์์ธ
- ๋ด๋ ํ์(๋ด์, ๋ด๋์)
- ๊ฐ์ข ์, ์ ์ด์
- ๊ณจ๋ค๊ณต์ฆ, ๊ตฌ๋ฃจ๋ณ, ๊ณจ์ก์ข
- ์์ (ํ๋ฐ์์ ALP ์ฆ๊ฐ)
๐ฉธ ์ ๊ธฐ๋ฅ ๊ด๋ จ ์์น
- ์ฃผ์ ์๋ฏธ: ๋จ๋ฐฑ์ง ๋์ฌ ์ฐ๋ฌผ(์์)์ ํ์ค ๋๋ → ์ ์ฅ ๋ฐฐ์ค๋ฅ ๋ฐ์
- ์์น ์์ธ
- ๊ธ์ฑ ์ ๋ถ์ , ๋ง์ฑ ์ ๋ถ์
- ํ์, ์ผํฌ (์ ํ๋ฅ ๊ฐ์)
- ๊ณ ๋จ๋ฐฑ ์์ด
- ์์ฅ๊ด ์ถํ (ํ์ก ๋จ๋ฐฑ์ง์ด ์ํ๋๋ฉฐ ์์ ์ฆ๊ฐ)
5. Creatinine (ํฌ๋ ์ํฐ๋)
- ์ฃผ์ ์๋ฏธ: ๊ทผ์ก ๋์ฌ์ฐ๋ฌผ, ์ฌ๊ตฌ์ฒด์ฌ๊ณผ์จ(GFR)๋ก ๋ฐฐ์ค → ์ ๊ธฐ๋ฅ ์งํ
- ์์น ์์ธ
- ๊ธ์ฑ ์ ์์ (์ฝ๋ฌผ, ๋ ์ฑ, ํ์ ๋ฑ)
- ๋ง์ฑ ์ ๋ถ์ (๋น๋จ๋ณ์ฑ ์ ์ฆ, ๊ณ ํ์์ฑ ์ ์งํ)
- ๊ทผ์ก์งํ (ํก๋ฌธ๊ทผ์ตํด์ฆ ๋ฑ)
- ๊ณ ๋ น, ํ์
โ ์ ๋ฆฌํ๋ฉด
- ALT·AST ↑ → ๊ฐ์ธํฌ ์์
- ALP ↑ → ๋ด๋ ํ์ ๋๋ ๋ผ ์งํ
- BUN·Creatinine ↑ → ์ ๊ธฐ๋ฅ ์ ํ(์ฌ๊ตฌ์ฒด ์ฌ๊ณผ์จ ๊ฐ์)
๐ฉบ ๊ฐ·์ ์ฅ ๊ธฐ๋ฅ ์์น ์์น ์์ธ ์ ๋ฆฌ
| ๊ตฌ๋ถ | ๊ฒ์ฌ๋ช | ์๋ฏธ ์์น | ์์น ์ ์์ธ ์งํ |
| ๊ฐ ๊ธฐ๋ฅ | ALT (Alanine Aminotransferase, ์๋ผ๋ ์๋ฏธ๋ ธ์ ์ดํจ์) | ๊ฐ์ธํฌ ์์ ์งํ | ๊ธ์ฑ/๋ง์ฑ ๊ฐ์ผ, ์์ฝ์ฌ์ฑ ๊ฐ์งํ, ์ง๋ฐฉ๊ฐ, ์ฝ๋ฌผ์ฑ ๊ฐ์์, ๊ฐ๊ฒฝ๋ณ, ๊ฐ์ |
| AST (Aspartate Aminotransferase, ์์คํ๋ฅดํ ์ดํธ ์๋ฏธ๋ ธ์ ์ดํจ์) | ๊ฐ, ์ฌ์ฅ, ๊ทผ์ก ์์ ๋ฐ์ | ๊ฐ์ผ, ์ง๋ฐฉ๊ฐ, ๊ฐ๊ฒฝ๋ณ, ๊ฐ์, ์ฌ๊ทผ๊ฒฝ์, ๊ทผ์ก ์์·๊ทผ์ก์งํ | |
| ALP (Alkaline Phosphatase, ์์นผ๋ฆฌ์ฑ ์ธ์ฐ๋ถํดํจ์) | ๋ด๋·๋ผ ์งํ ๋ฐ์ | ๋ด๋ ํ์(๋ด์·๋ด๋์), ๊ฐ์ข ์·์ ์ด์, ๊ณจ๋ค๊ณต์ฆ, ๊ตฌ๋ฃจ๋ณ, ๊ณจ์ก์ข , ์์ (์๋ฆฌ์ ์์น) | |
| ์ ๊ธฐ๋ฅ | BUN (Blood Urea Nitrogen, ํ์ก ์์ ์ง์) | ๋จ๋ฐฑ์ง ๋์ฌ์ฐ๋ฌผ → ์ ์ฅ ๋ฐฐ์ค๋ฅ ์งํ | ๊ธ·๋ง์ฑ ์ ๋ถ์ , ํ์, ์ผํฌ, ๊ณ ๋จ๋ฐฑ ์์ด, ์์ฅ๊ด ์ถํ |
| Creatinine (ํฌ๋ ์ํฐ๋) | ๊ทผ์ก ๋์ฌ์ฐ๋ฌผ → ์ฌ๊ตฌ์ฒด์ฌ๊ณผ์จ(GFR) ์งํ | ๊ธ์ฑ·๋ง์ฑ ์ ๋ถ์ , ๋น๋จ๋ณ์ฑ ์ ์ฆ, ๊ณ ํ์์ฑ ์ ์งํ, ๊ทผ์ก์งํ(ํก๋ฌธ๊ทผ์ตํด์ฆ), ํ์ |
โ ํ๋์ ์ ๋ฆฌ
- ALT·AST → ๊ฐ์ธํฌ ์์
- ALP → ๋ด๋/๋ผ ๋ฌธ์
- BUN·Creatinine → ์ ์ฅ ๊ธฐ๋ฅ ์ ํ
๐ง ๊ธฐํ
- ๋ํต, ํ๊ธฐ์ฆ, ๋ถ๋ฉด, ์ด์กฐ, ์ด์๊ฐ๊ฐ, ๊ฐ์ง ๋ฐ์ (์์ฃผ ๋๋ฌผ๊ฒ)
โ ํนํ ๋ฐ์ง, ํธํก๊ณค๋, ๋ถ๊ธฐ ๋ฑ์ ์ฆ์ ๋ณต์ฉ ์ค๋จํ๊ณ ๋ณ์ ๋ฐฉ๋ฌธ!
๐ซ 4. ์ฌ์ฉ์ ์ฃผ์์ฌํญ
โ ์ ๋ ๋ณต์ฉ ๊ธ์ง ๋์
- ๊ณผ๊ฑฐ ์ด ์ฝ ๋๋ ์ธํ๋ก์คํฌ๋ฆฐ๊ณ ํญ์์ ์ ๊ณผ๋ฏผ๋ฐ์ ๋ณ๋ ฅ ์๋ ํ์
- ํ๋์ค๋ฆฐ๊ณ ํญ์์ ์ ๊ต์ฐจ ๊ณผ๋ฏผ์ฑ ์๋ ํ์
- ์ค์ฆ ์ ์ฅ ์ฅ์ ํ์ (์์ฌ ํ๋จ ํ์)
โ ๏ธ ๋ณต์ฉ ์ฃผ์๊ฐ ํ์ํ ๊ฒฝ์ฐ
- ์์ฅ ์ฅ์ ๊ฐ ์ฌํ๊ฑฐ๋ ๊ธฐ์กด ๊ฐ์งํ, ํ์ก์งํ์ด ์๋ ํ์
- ๊ฒฝ๊ตฌ ์ญ์ทจ๊ฐ ์ด๋ ค์ด ํ์
- ๊ณ ๋ น์
- ์ ์์ ๋ฐ ์์ฐ๋ถ (์์ฌ์ ์์ ํ์)
๐งช 5. ์์ ๊ฒ์ฌ ๊ฒฐ๊ณผ์ ์ฝ๋ฌผ ์ํธ์์ฉ
๐งช ๊ฒ์ฌ ์์น์ ์ํฅ ์ค ์ ์์ด์!
- ํด๋ฆฌ๋ํ ์คํธ, ํ ๋ง์์ฝ, ์๋น๊ฒ์ฌ์ ์์์ฑ
- ์ง์ ์ฟฐ์ค ๊ฒ์ฌ์ ์์ฑ๋ฐ์ ๊ฐ๋ฅ
๐ ์ํธ์์ฉ ์ฝ๋ฌผ
- ํ๋ก๋ฒ ๋ค์๋: ๋ฐฐ์ถ ์ต์ → ํ์ค ๋๋ ↑
- ์ํ๋ฆฐ ๋ฑ ํญ์๊ณ ์ : INR ์์น ๊ฐ๋ฅ
- ํผ์์ฝ ํจ๊ณผ ๊ฐ์ ๊ฐ๋ฅ์ฑ
๐งพ ๊ฒฐ๋ก : ํญ์์ , ์ ์คํ๊ฒ ๊ทธ๋ฆฌ๊ณ ์ ํํ๊ฒ
๋ฉ๋์นด์ธํํด๋ฌ์บก์250mg์ ์ ๋ขฐ๋ฐ๋ ํญ์์ ์ค ํ๋์ ๋๋ค.
ํ์ง๋ง, ๊ทธ๋งํผ ์ฌ์ฉ ์ ์ฃผ์์ฌํญ๋ ์ฒ ์ ํ ์ง์ผ์ผ ํฉ๋๋ค.
๋ฌด์๋ณด๋ค ์ค์ํ ๊ฒ์ ์์ ๋ณต์ฉ ๊ธ์ง!
๐ ์ฆ์์ด ํธ์ ๋๋๋ผ๋ ๋๊น์ง ๋ณต์ฉํ๊ณ , ์ด์ ๋ฐ์์ด ์๋ค๋ฉด ์ฆ์ ์ ๋ฌธ๊ฐ์ ์๋ดํ์ธ์.
โ Q&A: ๊ถ๊ธํ ํญ์์ ์ด์ผ๊ธฐ
Q1. ๋ฉ๋์นด์ธํํด๋ฌ๋ ๊ฐ๊ธฐ์ ์ข๋์?
โ ์๋๋๋ค. ๊ฐ๊ธฐ๋ ๋ฐ์ด๋ฌ์ค์ฑ ์งํ์ด๋ฏ๋ก ํญ์์ ๋ก ์น๋ฃ๋์ง ์์ต๋๋ค. ๋ค๋ง 2์ฐจ ๊ฐ์ผ์ด ์์ ๊ฒฝ์ฐ ์ฒ๋ฐฉ๋ฉ๋๋ค.
Q2. ์์ฅ์ฅ์ ๊ฐ ์๋๋ฐ ๋ณต์ฉํด๋ ๋๋์?
๊ฐ๋ฅ์ ํ์ง๋ง ์ฃผ์๊ฐ ํ์ํฉ๋๋ค. ์ฌํ ๊ฒฝ์ฐ ์ํ ๋ณต์ฉํ๊ฑฐ๋, ๋์ฒด ์ฝ๋ฌผ ์๋ด์ด ํ์ํฉ๋๋ค.
Q3. ๋ณต์ฉ์ ์์์ด์! ์ด๋ป๊ฒ ํ๋์?
๋ฐ๊ฒฌ ์ฆ์ ๋ณต์ฉํ๊ณ , ๋ค์ ๋ณต์ฉ ์๊ฐ์ด ๊ฐ๊น์ฐ๋ฉด ์์ ๋ณต์ฉ์ ๊ฑด๋๋ฐ์ธ์. ์ ๋ 2๋ฐฐ ์ฉ๋ ๋ณต์ฉ ๊ธ์ง!
Q4. ์์ฐ๋ถ๋ ๋จน์ ์ ์๋์?
ํ์ ์ ์์ฌ์ ํ๋จ ํ์ ์ฌ์ฉํ ์ ์์ง๋ง, ์์ ๋ณต์ฉ์ ์ ๋ ๊ธ์ง์ ๋๋ค.
Q5. ํญ์์ ๋ฅผ ๋์ผ๋ฉด ์ ๋๋ค๋๋ฐ, ์์?
์ค๊ฐ์ ๋์ผ๋ฉด ์ธ๊ท ์ด ์ด์๋จ์ ๋ด์ฑ๊ท ์ผ๋ก ๋ณํ ์ ์์ต๋๋ค. ์น๋ฃ ์คํจ๋ก ์ด์ด์ง ์ ์์ผ๋ ๊ผญ ์ฒ๋ฐฉ๊ธฐ๊ฐ ์ค์ํ์ธ์.
๋ฉ๋์นด์ธํํด๋ฌ์บก์250mg์
์ ํํ ํจ๋ฅ๊ณผ
๋ณต์ฉ๋ฒ, ๋ถ์์ฉ, ์ฃผ์์ฌํญ์
์๋ฒฝ ์ ๋ฆฌ.
๊ฐ์ผ ์งํ ์น๋ฃ์
ํจ๊ณผ์ ์ธ ํญ์์ ์ ๋ณด ์ด๋ง๋ผ!
๐จโ๏ธ ์ฝ ๋ณต์ฉ ์ ํ๋ก ๊ถ๊ธํ ์ ์ด ์๋ค๋ฉด ๋ง์ค์ด์ง ๋ง๊ณ ์ ๋ฌธ๊ฐ ์๋ด์ ๋ฐ์ผ์ธ์.
๐ฑ ๊ทธ๋ฆฌ๊ณ ์ด ๊ธ์ด ๋์์ด ๋์
จ๋ค๋ฉด, ์๋ ๋ฒํผ์ผ๋ก ๊ณต์ ๋ถํ๋๋ฆฝ๋๋ค!
'๐์์ฝํ' ์นดํ ๊ณ ๋ฆฌ์ ๋ค๋ฅธ ๊ธ
| ๋ฌผ๋๋ผ๋ฏผ์์ค๊ฒ ํจ๋ฅ ๋ถ์์ฉ ์ฌ์ฉ๋ฒ (0) | 2025.09.08 |
|---|---|
| ์ฌ๋ฉ๋ก ์ ํจ๋ฅ, ๋ถ์์ฉ, ๋ณต์ฉ๋ฒ (0) | 2025.09.06 |
| ํธ๋ก๋์ธํฌ๋ฆผ(30g) ํจ๋ฅ, ๋ถ์์ฉ, ๋ณต์ฉ๋ฒ (0) | 2025.08.29 |
| ์๋ฅดํ์ ํจ๋ฅ ๋ถ์์ฉ ๋ณต์ฉ๋ฒ (3) | 2025.08.27 |
| ์ธํธ๋ผ๋ฆฌํผ๋10%์ฃผ ํจ๋ฅ ๋ถ์์ฉ ๋ณต์ฉ๋ฒ (2) | 2025.08.25 |